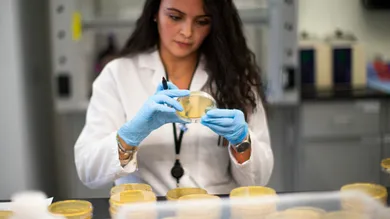
Kena Betancur/Getty Images

A person has died in Washington state of the Coronavirus reports The Associated Press. Kayse Dahl, a spokesperson for EvergreenHealth Medical Center, said the person died in a facility in the Seattle suburb of Kirkland, but gave no other details. President Trump described the victim as a “wonderful woman” in her late 50s that was a “medically high-risk patient.” According to the Washington Post, The Trump administration on Saturday announced additional travel restrictions affecting Iran, Italy, and South Korea in response to the coronavirus outbreak, following the first death from the virus in the United States.
Washington Gov. Jay Inslee said in a statement that the person who died was a male before rescinding that comment and replacing the gender with the term Washingtonian. “We will continue to work toward a day where no one dies from this virus,” he stated. Washington state and King County health officials are reporting that “new people (have been) identified with the infection, one of whom died.” The number of coronavirus victims was not disclosed. In a phone interview with the AP, Amy Reynolds of the Washington state health department stated, “We are dealing with an emergency evolving situation.” We will continue to update this story as it unfolds.